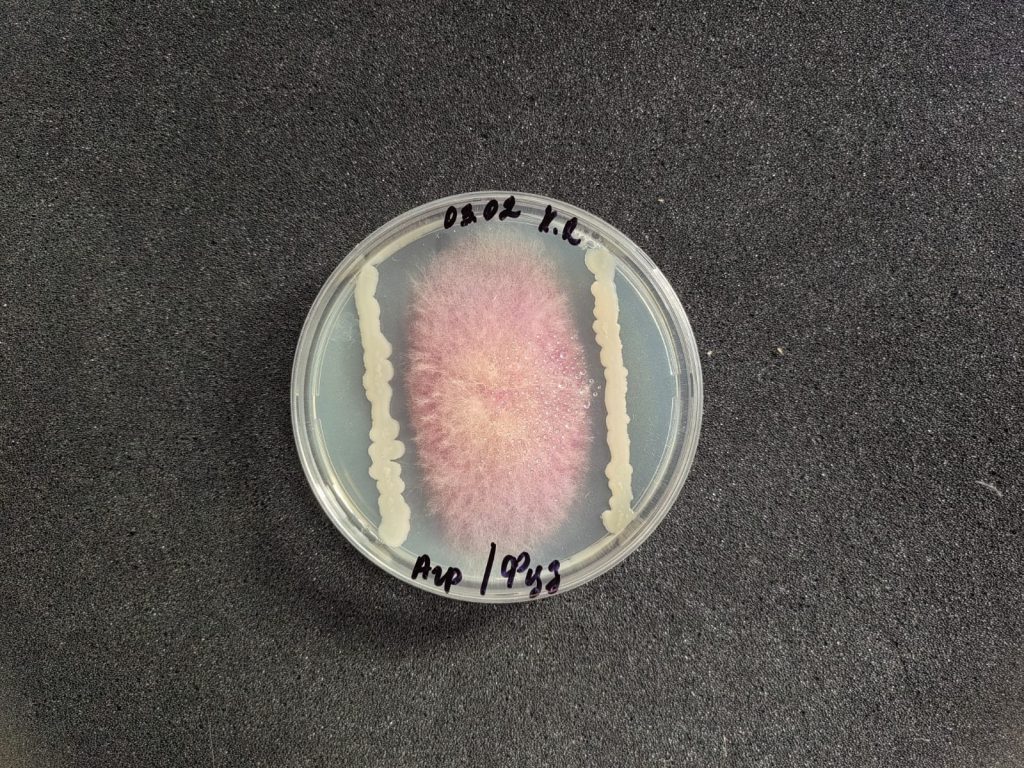

Сегодня помимо сохранения и повышения урожайности особое внимание уделяют экологическому аспекту возделывания сельскохозяйственных и технических культур. Сегодня помимо сохранения и повышения урожайности особое внимание уделяют экологическому аспекту возделывания сельскохозяйственных и технических культур. Выпускается группа биопрепаратов пролонгированного действия для инокуляции семян бобовых культур – гороха, сои, чечевицы.

Рисунок 1. Результаты проверки подавления гриба рода Alternaria бактериями рода Bacillus
Методы защиты растений ежегодно модернизируются и развиваются. Основу защиты растений от патогенной микрофлоры составляют химические фунгициды, однако, все чаще можно встретить, как помимо химических протравителей используются биологические препараты. Это связано с тем, что несмотря на большую эффективность химических препаратов, для защиты урожая от грибов и оомицетов часто требуется многократная обработка фунгицидами, что в свою очередь может привести к устойчивости патогенов к действующим веществам химических протравителей. Резистентность к возбудителям заболеваний растений ведет к массовым потерям урожая, при этом многократное увеличение дозировки препаратов малоэффективно и экономически неоправданно. В связи с этим, в современном растениеводстве распространяется тенденция к сокращению количества фунгицидов. Проблема резистентности патогенов к химическим фунгицидам актуальна и исследуется повсеместно, разрабатываются различные методы борьбы с ней, основные: применение хемосенсибилизирующих препаратов, направленных на увеличение чувствительности патогена к фунгициду, выбор устойчивых сортов к тем или иным патогенам, чередование химических протравителей, соблюдение севооборота. Также перспективным и широко используемым является биометод – это метод, основанный на применении биологических агентов, обладающих фунгицидной/бактерицидной активностью. Важно отметить, что такой вид препаратов безопасен для растений и почвы, нетоксичен для урожая и потребителя. Как правило, биопрепараты в основе своей содержат почвенные микроорганизмы, выделяющие вещества, подавляющие рост и развитие патогена. Кроме того, бактерии, попадая в почву, их естественную среду обитания, и размножаясь, с высокой скоростью заполняют почвенное пространство, не оставляя достаточного пространства патогенам для развития. Поэтому важно помнить, что применение бактериальных препаратов наиболее эффективно при обработке семян перед посевом. Однако обработка растений по листу на разных стадиях развития также полезна.

Препарат «Гуминатрин концентрат с микроэлементами» помимо элементов минерального питания содержит в себе комплекс бактериальных культур, которые улучшают рост, развитие растений, помогают усваивать макро- и микроэлементы, а также, некоторые из этих культур помогают бороться с грибными патогенами.
Сейчас в состав препарата входят несколько штаммов Bacillus subtilis и Bacillus amyloliquefaciens.
Каждый штамм проходит проверку на наличие антагонистической активности по отношению к грибным патогенам. По литературным данным B. subtilis обладает супрессивными качествами in vitro по отношению более чем к 20 типам фитопатогенных организмов за счет способности продуцировать вторичные метаболиты, например, липопептидный антибиотик – сурфактин, циклические липогептапептиды: микосубтилин, итурин, бацилломицин. Вещества, выделяемые сенными палочками, могут быть общими для вида, а могут быть специфичны в зависимости от штамма. Также существует специфичность вещества к патогену. Различные исследования показывают наличие супрессивной активности Bacillus subtilis к грибам родов Fusarium, Candida, Aspergillus, Botrytis, Alternaria, Phytophtora.
Bacillus amyloliquefaciens, как и Bacillus subtilis – вид широко изучаемый. Существуют множество исследований о фунгицидном потенциале штаммов этого вида бактерий. Bacillus amyloliquefaciens активные продуценты ферментов альфа-амилазы, субтилизина и др. Как и Bacillus subtilis описываемый вид способен выделять вещества: бацилломицин, сурфактин, итурин, амилолизин, фенгицин. Также синтезирует собственный антибиотик барназу.



Препараты на основе Bacillus amyloliquefaciens применяют и в растениеводстве, и в животноводстве. Для растений этот вид бактерий выступает как стимулятор роста и защитный агент. Штаммы вида способны подавлять рос и развитие таких патогенов как: Alternaria tenius, Aspergillus niger, Fusarium graminearum, Fusarium solani, Fusarium culmorum, Fusarium avenaceum, Fusarium sporotrichioides, Microdochium nivale, Phomopsis helianthi, Phoma solanicola, Phytophtora infestans, Rhizoctonia solani, Sclerotinia sclerotiorum. Помимо фунгицидной известна и бактерицидная активность вида в отношении бактерий: Bacillus cereus, Bacillus thuringiensis, Bacillus subtilis, Bacillus megaterium, Staphylococcus ssp., Streptococcus ssp., Pseudomonas aureofaciens, Pseudomonas corrugata, Pseudomonas marginata, Erwinia cnrysanthemi, Xanthomonas campestris.
На данный момент в условиях нашей лаборатории проведена проверка фунгицидной активности бактерий Bacillus amyloliquefaciens и Bacillus subtilis против грибов рода Fusarium, Alternaria, Aspergillus, Sclerotinia.
Ежегодное применение «Гуминатрина» (обработка семян + трёхкратная подкормка по листу) позволяет исключить из схемы работы зерновых культур химический фунгицид или, снизить его дозировку в 2-5 раз.
Партнерский материал
Реклама, ЕРИД: 2Vtzqx9Gjp5, ООО «СИБАГРОСЕРВИС», 5501169303
